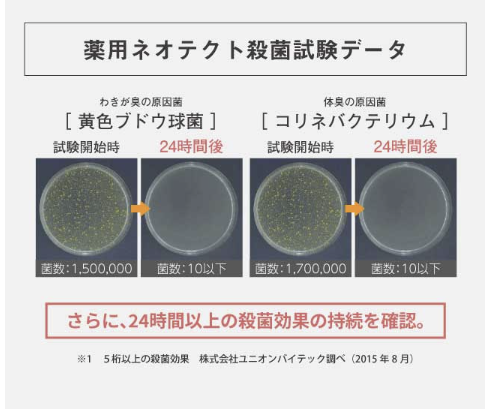
殺菌作用が24時間以上持続

休みの前日、スマホいじって気づいたら日付が変わってた。
そんな休日、もう何回目ですか。
別に寂しいわけじゃない。 ただ、今日や休日に会える女性を見つけたい。
私は合コンも職場もダメで、出会い系を10年以上使っています。でもサクラに50万以上は使ったし、「将来のために投資しない?」とか言ってくるロマンス詐欺まがいの女性にも引っかかりかけた40代の男です。
何度もアプリを消しました。
そのたびに「もうしない」って思ってたんです、私も。
でも本当に全部ダメなのか、自分の目で確かめたくて大手アプリにも挑戦。
PCMAX・ハッピーメール・ワクワクメール・Jメール・イククル。 全部に自腹で課金して、検証しました。
この記事は、私が女性と出会えるまでの記録です。
5分だけ読んでください。
読み終わる頃には、どれに登録すればいいか決まっています。

フレグランスジャーナル編集者・40代男性
出会い系歴13年以上。サクラにも詐欺にも一通り引っかかりました。その経験を生かして今は、自分に合うアプリを見つけて普通に会えてます。
全部試した上であなたのために正直に書いてます。
正直言って40代でもアプリで出会える?
結論からお伝えします。出会えます。
ただし「場所」を間違えると、会えません。 私がそうだったので、間違いないです。
若い男性がライバル|それ、アプリの選び方が間違ってます
最初に言っておきたいことがあります。
「マッチングアプリ」と「出会い系アプリ」は、似ているようで用途がちがいます。
Pairsやwith、タップルみたいないわゆる恋活・婚活向けのマッチングアプリ。
あれは20代〜30代前半の男女が「彼氏・彼女がほしい」って目的で使う場所です。
プロフィールにはキラキラした写真が並んでて、趣味は「カフェ巡り」「旅行」。
正直、40代の男性が開いた瞬間「ここは俺の場所じゃないな」って思います。
私も最初そうでした。とりあえず有名だからってタップルに登録して、いいねを送りまくって、返ってきたのは外部業者2人。30人送ってたったの2人です。

あの時は「やっぱり40代は無理なんだ」と思いました。でも、それは間違いでした。
場所が間違っていただけです。
PCMAXやハッピーメール、ワクワクメールのような出会い系アプリは、そもそもの目的が違います。
「恋人探し」じゃなくて、「大人同士が目的を持って会う場所」。年齢層も全然違う。
ここに来てようやく、40代の自分でも普通にやりとりができるようになりました。
出会い系の主戦場、じつは30代〜50代
| アプリ名 | 累計会員数 | 運営歴 | 男女比 |
|---|---|---|---|
| PCMAX | 2,000万人 | 20年以上 | 7:3 |
| ハッピーメール | 3,500万 | 25年以上 | 6:4 |
| ワクワクメール | 1,300万人 | 22年以上 | 約5:5 |
| Jメール | 1,000万人 | 20年以上 | 約6:4 |
| イククル | 1,500万人 | 20年以上 | 約7:3 |

これ、意外に思うかもしれません。
出会い系アプリも、若い子がいそうなイメージがありませんか? 実際は逆です。
各アプリの女性会員の年齢層を調べてみると、はっきりした数字が出ています。

PCMAXの女性会員で30代以上は約33%。3人に1人が30代以上です。ハッピーメールに至っては30代以上が約39%、ほぼ4割。
さらに注目したいのがイククルでは、30代〜50代の利用者が大半を占めています。
つまり、40代の男性がいても「場違いだな」とは感じない。むしろ、ここではあなたが主力層です。
「登録しても誰もいないんじゃないか」その不安もわかります。
でも、ハッピーメール公式サイトによると、1日あたりの募集閲覧は45万回以上、メッセージのやりとりは1日85万回以上。
PCMAXもアクティブ会員が60万人を突破しています。
登録だけして放置されているようなサービスではありません。

以上のことを踏まえて、
20代は恋活・婚活向けのマッチングアプリに行く。SNS経由の出会いもある。
出会い系をわざわざ使う必要がないんです。
でも30代後半を過ぎると、そういう出会いの場がなくなってくる。
仕事が忙しい、子育てが一段落した、離婚したなど。
いろんな事情で「手っ取り早く、目的が合う相手と会いたい」と思った大人が集まるのが出会い系です。
だから40代の男性がいても、まったく浮かない。むしろ、ここが主戦場です。
恋愛ごっこは不要|40代男性が「目的の合う相手」を見つけやすい理由
ここが一番大事なポイントかもしれません。
恋活・婚活向けのマッチングアプリだと「まずはメッセージで仲良くなって、デートを重ねて、お互いの気持ちを確認して」みたいな段階を踏まないといけない。
正直、そういうのが面倒だと感じている人は多いと思います。私もそうです。
出会い系アプリの良いところは、お互いの目的がはっきりしていること。
今すぐ会いたい人は「今すぐ会いたい」と書いてある。
条件がある人は条件を出している。
まどろっこしいやりとりを飛ばして、大人同士がお互いの条件を確認して会う。それだけの話です。
40代の男性は、ここで実はかなり有利な立場にいます。
理由はシンプルで、経済力と落ち着きがあるから。
20代の男性にはないものを、あなたはすでに持っているんです。
年下の女性との出会い、同年代の女性との割り切った関係、既婚者同士の大人の付き合い。
どれも、出会い系アプリなら目的に合った相手が見つかりやすい。それは、お互いが最初から同じ方向を向いているからです。
どんなアプリを選べばいいの?選び方は3つだけ
ここまで読んで「よし、ちょっとやってみるか」と思ってくれた人もいるかもしれません。
でも次に出てくるのが「で、どれを選べばいいの?」という疑問ですよね。
出会い系アプリは数が多いし、比較サイトを見ても情報が多すぎて逆にわからなくなる。
なので、ここではシンプルにいきます。見るべきポイントは3つだけです。
この3つを押さえておけば、「ハズレ」はないです。
チェック① 会員数が1,000万人以上で同年代の女性がきちんといるか

これが一番大事です。
どれだけ会員数が多くても、男女ともに20代ばかりのアプリに40代の男が入ったら空振りになります。
さっき話した「マッチングアプリで30人にいいねして業者2人だった件」っていう私の失敗談、まさにこれです。
確認の方法は簡単で、登録したあとにプロフィール検索で年齢を「30代〜40代」に絞ってみてください。
そこにちゃんと女性が表示されるかどうか。それだけ見ればいいんです。
先ほどデータでもお見せしましたが、改めて整理すると
今回おすすめするアプリすべて会員数の累計が1,000万超えています。
また、PCMAXは女性会員の33%が30代以上。 ハッピーメールは39%。イククルに至っては30代〜50代が大半です。
逆に、PairsやTappleは20代の恋活・婚活メインの男女が中心。40代の男性が使うステージじゃない。
ここを間違えなければ、まず大きな失敗はしません。
チェック② 登録が簡単ですぐ使えるのか

中高年の男性にとって、登録の手間は想像以上にハードルが高いです。
「顔写真必須」「審査に3日かかります」「マイナンバーカードで本人確認」こういうのが出てくると、面倒になってそこでやめてしまう人が本当に多い。
私がおすすめするアプリは、どれも登録が3分以内で終わります。
メールアドレスか電話番号、年齢確認の身分証、基本はこれだけ。写真も最初は載せなくて大丈夫です。
(でも写真は女性に安心してもらうために必要なのでなるべく面倒臭がらないでほしいです)
「とりあえず中を覗いてみたい」が、ちゃんとできるアプリを選んでください。
登録が簡単だからと言っても「24時間監視体制」など偽アカウント排除への取り組みは徹底しています。
| サービス名 | 公安委員会届出 | 監視体制 | 本人確認・年齢認証 | その他の特徴 |
|---|---|---|---|---|
| PCMAX | 済み | 24時間365日有人監視 | セルフィー認証・年齢確認必須 | 業者通報・ペナルティ制度、保護マーク取得 |
| ハッピーメール | 済み | 24時間常時監視 | 本人確認・年齢確認必須 | 自動ブロック機能、18禁徹底、TRUSTe認証 |
| ワクワクメール | 済み | 24時間365日パトロール | セルフィー認証・年齢確認必須 | JAPHIC保護マーク、AI監視試験導入、悪質書き込みブロック |
| Jメール | 済み | 24時間監視体制 | 本人確認・年齢確認必須 | 通報対応・強制退会、個人情報保護強化 |
| イククル | 済み | 常時監視・サポート | 本人確認・年齢確認必須 | 業者排除・ペナルティ、24時間対応 |
しかも、登録特典で無料ポイントがもらえて試せるので入口のハードルが低いかどうかは、大事なポイントです。
チェック③ 無料ポイントでお試しできるか
出会い系アプリはほとんどがポイント制です。
メッセージを送る、プロフィールを見る。こういった操作にポイントが必要になる。
そこで、この部分が大事なんですが、まともなアプリは登録するだけで無料ポイントがもらえます。
これ、運営側からしたら「まず使ってみてくれれば良さがわかるから」っていう自信の表れなんですよね。
各アプリでもらえる無料ポイントを整理すると、
| アプリ | 無料ポイント(登録時) | できること |
|---|---|---|
| PCMAX | 約700円分 | メッセージ約14通分 |
| ハッピーメール | 約1,200円分 | メッセージ約24通分 |
| ワクワクメール | 約1,700円分 | メッセージ約34通分 |
| Jメール | 約1,000円分 | メッセージ約14通分 |
| イククル | 約800円分 | メッセージ約16通分 |
つまり、5つ全部に登録するだけで、合計5,000円以上の無料ポイントがもらえる。1円も払わずに「どのアプリが自分に合うか」を試せるわけです。
私のおすすめは、最初から1つに絞らないこと。
2〜3個は併用して、無料ポイントで雰囲気を確かめてから、自分に合ったアプリにお金を使う。これが一番失敗しない方法です。
この3つさえ確認すれば、アプリ選びで失敗することはまずありません。
逆に言えば、この3つを全部クリアしてるアプリだけを選べばいい。
では、ここから先は実際に全部使った私が、本音でランキングにします。
【実際に使っている】40代男性におすすめの出会い系アプリ5選
ここからは、私が実際に全アプリに自腹で課金して検証した結果です。
良いことも悪いことも、全部書きます。
このおすすめの出会い系アプリはどれもずっと使っています。
1位 PCMAX|40代が一番動きやすい。迷ったらここ
| こんな人向け | とにかく早く会いたい 回りくどいやりとりが苦手 |
| 40代男性の使いやすさ | |
| 無料でできること | 登録で約700円分のポイント=メッセージ約14通分 |
| 筆者の本音 | 5つのアプリを全部使った上で、40代男性が「最初の1つ」として選ぶなら、PCMAXが一番だと感じました。 理由はシンプルで、「目的が合う相手」が見つけやすいから。 ![]() PCMAXには「いまヒマ」という機能があって、今すぐ会える人だけを探せます。回りくどいメッセージのやりとりを飛ばして、直接会う約束まで持っていけるんです。 |
| 会員数・年齢層 | ・累計会員数は2,000万人以上。 ・女性会員の33%が30代以上 ・アクティブ会員も60万人を超えていて、地方でも相手が見つかる。 |
| 安全性 | ・24時間365日の有人監視体制 ・公安委員会に届出済み ・運営歴20年以上の老舗 |
| 弱点 | プロフィールの閲覧にポイント(10円)がかかる ※気になる相手だけ見る |
\ すぐ会える女性が圧倒的No.1アプリ/
2位 ハッピーメール|会員数の暴力。母数が正義
| こんな人向け | いろんなタイプの女性と出会いたい 地方に住んでいる |
| 40代男性の使いやすさ | |
| 無料でできること | 登録で約1,200円分のポイント=メッセージ約24通分。 ※初回のポイントも5アプリ中2番目に多いので、無料の範囲だけでもかなり動けます。 |
| 筆者の本音 | ハッピーメールの最大の武器は、累計会員数3,500万という圧倒的な数です。 これがなぜ大事かというと、出会い系は「母数」がすべてだからです。どれだけ機能が良くても、人がいなければ意味がない。ハッピーメールは、人がいる。それも圧倒的に。 ![]() ハッピーメールは「ミドルシニア」専用の掲示板もあるので、40代以上の出会いに特化した使い方ができます。 PCMAXと比較すると、ハッピーメールはプロフィール閲覧が無料なのが大きい。気になる女性を気兼ねなくチェックできる。 |
| 会員数・年齢層 | ・累計会員数は3,500万以上。 ・女性会員の39%が30代以上 ・男女比も6:4でバランスが良く、1日のメッセージ送信数が85万回以上 ・募集の閲覧は45万回以上 |
| 安全性 | ・24時間365日の有人監視体制 ・公安委員会に届出済み ・運営歴25年以上 |
\ どこにいても会える会員数3,500万の存在感!/
3位 ワクワクメール|安全性で選ぶなら、ここが一番
| こんな人向け | 過去に騙された経験がある とにかく安全に使いたい |
| 40代男性の使いやすさ | |
| 無料でできること | 【業界最多】 登録で約1,700円分のポイント=メッセージ約34通分 |
| 筆者の本音 | ![]() ワクワクメールの最大の特徴は、「セルフィー認証」という独自の本人確認システムです。 身分証と自分の顔を一緒に撮影して送る。これをクリアした相手だけに絞ってやりとりすれば、業者やなりすましに引っかかるリスクが格段に下がる。 過去に出会い系で痛い目に遭った人。つまり、私みたいな人間にとっては、この安心感はかなり大きい。 |
| 会員数・年齢層 | ・累計会員数は1,300万人 ・女性の年齢層は20代が中心 ・40代前半に第二のピーク ※なぜなら既婚者でも登録できるため、子育てが一段落した30代後半〜40代の女性が増えているから |
| 安全性 | ・24時間365日の有人監視体制 ・公安委員会に届出済み ・運営歴25年 |
| 弱点 | 会員数がPCMAXやハッピーメールに比べるとやや少ない ※PCMAXかハッピーメールとの併用おすすめ |
\ 大丈夫だって思える独自認証の安心感!/
4位 Jメール|地方の40代は、この穴場を知らないと損
| こんな人向け | 地方在住 九州にゆかりがある 派手めの女性が好み |
| 40代男性の使いやすさ | |
| 無料でできること | 登録で約1,000円分のポイント=メッセージ約14通分 |
| 筆者の本音 | Jメールの運営会社は福岡にあって、九州での知名度がかなり高い。九州在住の人、あるいは出張で九州に行く機会がある人にとっては、他のアプリより出会える確率が上がります。![]() しかも、Jメールには「誘い飯掲示板」という機能があって、「今日一緒にごはん行きませんか」みたいな気軽な誘いから始められる。 |
| 会員数・年齢層 | ・累計会員数は1,100万=穴場 ・年齢層が幅広いこと(20代〜50代まで) |
| 安全性 | ・24時間365日の有人監視体制 ・公安委員会に届出済み ・運営歴20年以上 |
| 弱点 | 都市部ではPCMAXやハッピーメールのほうが効率が良いこと。 ※PCMAXかハッピーメールとの併用おすすめ |
\ 中高年が選ばれる出会いの穴場アプリ!/
5位 イククル|2つ目に入れるサブとして最強

| こんな人向け | メインのアプリと併用したい 同年代〜年上の落ち着いた女性と会いたい |
| 40代男性の使いやすさ | |
| 無料でできること | 登録で約800円分のポイント=メッセージ約16通分 |
| 筆者の本音 | イククルを5位にしたのは、「メインで使うアプリ」としてはやや弱いから。でも、「サブで入れておくアプリ」としてはこれ以上ないくらい優秀です。 理由は、イククルの年齢層が他のアプリと明らかに違うから。 他のアプリで「若い子ばかりで気後れする」と感じた経験がある人は、イククルを開いた瞬間に空気が違うことに気づくと思います。同年代の女性が多いので、メッセージの温度感も落ち着いていて、やりとりがしやすい。 |
| 会員数・年齢層 | ・累計会員数は1,500万人 ・30代〜50代が大半 |
| 安全性 | ・24時間365日の有人監視体制 ・公安委員会に届出済み ・運営歴20年以上 |
| 弱点 | アクティブユーザー数がPCMAXやハッピーメールに比べると少ないこと。 ※PCMAXかハッピーメールとの併用おすすめ |
\ 中高年が活動しやすい最強のサブアプリ!/
登録したあと、最初にやるべきこと
アプリに登録した。で、何をすればいいの?
ここでつまずく40代男性、ものすごく多いんです。
登録はしたけど、プロフィールが空欄のまま。写真もない。何を書けばいいかわからない。結局そのまま放置。
これ、一番もったいないパターンです。
なので、最初にやるべきことを4つだけに絞りました。上から順番にやってください。
① プロフィール写真は「清潔感」だけでいい
40代の男が一番悩むのが写真です。
「もう若くないし」「イケメンじゃないし」「写真撮り慣れてないし」わかります。
全部わかる。でも、安心してください。
出会い系の写真で求められてるのは「イケメンかどうか」じゃない。「この人、ちゃんとしてるな」と思わせることです。
それだけ。本当にそれだけなんです。

| 撮り方 | スマホのインカメラで、胸から上を撮る。窓際か明るいカフェで。自然光が最強 |
| 服装 | 無地のシャツか、襟付きのポロシャツ。ユニクロで十分。清潔感があればいい。 |
| 表情 | 無理に笑わなくていい。口角をほんの少し上げるだけで、印象がまるで違います。 |
| 絶対にやめてほしいこと | ・なるべくならマスクはせずにモザイク加工で口元隠す ・トイレの鏡で撮る → 生活感が出すぎる ・5年前の写真を使う → 会ったときに「誰?」となって終わる ・加工しすぎる → 40代の男がSnowを使うと逆効果 |
私自身、最初はスーツの証明写真を載せてました。反応はゼロ。
カフェで撮った私服の写真に変えたら、その週にメッセージが3件来たんです。

写真を変えるだけで、本当に変わります。
② 【コピペOK】自己紹介文は3ヶ所だけ変えればいい
自己紹介文もハードルが高いですよね。何を書けばいいかわからない。長すぎてもダメ、短すぎてもダメ。
なので、テンプレートを用意しました。この文章をコピペして、【 】の部分を自分の情報に変えるだけでOKです。
はじめまして。都内で【 仕事(例:営業) 】の仕事をしている【 年齢 】歳です。
【 自分の状況を一行で(例:最近仕事が落ち着いてきたので) 】、気軽に会える人がいたらいいなと思って登録しました。
【 好きなこと(例:お酒が好きで、週末はよく一人で飲み歩いてます) 】。
まずはメッセージからお話しできたら嬉しいです。よろしくお願いします。
このテンプレが効く理由は3つ。
まず、仕事を書いている。
40代の男が仕事を書いてるだけで「ちゃんとした人」に見える。具体的な社名は不要。「営業」「IT系」「メーカー勤務」くらいで十分。
次に、登録した理由を正直に書いている。
「気軽に会える人がいたらいいな」は、目的をぼかしすぎず、かつ下品にもならないギリギリのライン。
この一文があると「この人はなんでこのアプリにいるんだろう」という女性側の警戒心が消えます。
最後に、短い。
自己紹介は長ければいいってもんじゃない。
女性はプロフィールを大量に見ています。5〜6行でパッと内容が伝わるほうが、最後まで読んでもらえます。
くれぐれも「年収〇〇万」「車は〇〇」「タワマン住み」みたいなスペック自慢は書かないでください。
40代の男がそれをやると、女性からは「金で釣ろうとしてる」か「見栄っ張り」にしか見えません。
③ 40代の男が意外と見落とす「におい」について
プロフィール写真を整えて、自己紹介を書いて、メッセージをやりとりして。
いざ実際に会うことになった。ここまで来たら、もう90%は成功です。
でも、残りの10%で台無しにする40代男性が本当に多いんです。
原因は「におい」です。
自分では気づかない。でも相手は一瞬で気づく。
これが40代男性の加齢臭問題です。
誤解しないでほしいんですが、「お前は臭い」と言いたいわけじゃないです。
40代になると、体質的にどうしても体臭が変化します。これは生理現象で、誰にでも起こること。
ただ、「知ってるかどうか」で対策が変わるし、対策すればある程度はカバーできるんです。
まずやるべきは「香りをつける」前に「臭いを消す」こと。
ここを間違えてる男性がものすごく多いです。
体臭の上から香水をかけても意味がない。むしろ混ざって悪化します。
具体的な手順は3つだけ:
これだけで体臭の8割は消えます。当たり前に聞こえますが、冬場はシャワーを浴びずに出かける男性が意外と多いので気を付けてください。
ウルトラファインバブルの強力な洗浄力で毛穴の奥の皮脂汚れを掻き出すため、加齢臭や頭皮のニオイ、体臭の改善に効果的です。
毛穴より小さな泡がニオイの元となるノネナールや皮脂を落とす点、耳裏や頭皮に効く「スプラッシュストレート」モードがあります。



\ 今だけ初回12%OFF!浴びる度清潔になる/
加齢臭をカバーするために強い香りの制汗剤を使う人がいますが、これは逆効果です。無香料のデオドラントで汗と雑菌を抑えるのが先。
殺菌・制汗・防臭の3つの効果で、わきが(腋臭)や体臭、加齢臭を元から防ぐ医薬部外品のクリームタイプ制汗剤です。
菌の増殖を約6時間後で99.9%以上抑制する高い防菌力と、汗を抑える高密着処方が特徴で、全身のニオイケアに使用できます。
アシタバエキス・オウゴンエキスといった9つの成分で皮膚を保護し、プラセンタエキス・ヨクイニンエキスといった6つの成分で乾燥を防ぎ、ワレモコウエキス・メントールといった3つの成分で肌のキメを整えます。

\ 今だけ初回63%OFF!殺菌・制汗・防臭の3役/
40代の男性に似合うのは、ウッディ系かシトラス系のさりげない香り。甘すぎる香水はホストっぽくなるし、つけすぎるとエレベーターで隣に立つだけで迷惑になる。
つけるなら手首の内側に1プッシュだけ。
正面からは香らないけど、隣を歩いたときにふわっと香る。これが「あ、この人いい匂いする」と思わせるラインです。

ただ一つだけ断言できるのは、40代男性にとって「においケア」は写真やメッセージと同じくらい大事ということです。
どんなにプロフィールが良くても、会ったときに「うっ」と思われたら二度目はない。
逆に、清潔感のある香りがするだけで「この人、ちゃんとしてるな」という印象が一気に上がります。
④ メッセージを続けてもらうコツは「質問で終わる」こと
メッセージのコツは山ほどありますが、全部忘れていいです。一つだけ覚えてください。
メッセージの最後を、必ず質問で終わらせる。
これだけで返信率が段違いに変わります。
なぜかというと、質問で終わっているメッセージは「返信しやすい」からです。
人間は質問されると答えたくなる。逆に、「よろしくお願いします」で終わるメッセージには、何を返していいかわからない。
ダメな例
はじめまして。プロフィール見て気になりました。お酒が好きなんですね。よろしくお願いします。
いい例
はじめまして。プロフィール見て気になりました。お酒が好きなんですね。最近行って良かったお店とかありますか?
変えたのは最後の一文だけです。でもこれだけで、相手は「あ、〇〇ってお店が良かったよ」と返しやすくなる。
メッセージテクニックは他にもいろいろありますが、40代の男性が覚えるべきなのはこれだけで十分です。
小手先のテクニックより、「相手が返信しやすいかどうか」を考えるほうがずっと大事。
それに、40代の男がこまめにスタンプを送ったり、絵文字を多用したりすると、正直キツい。落ち着いた文章で、最後に質問を一つ入れる。これが40代の男の武器です。
まとめ|40代男性におすすめのマッチングアプリは5種類の出会い系サービスである
最後まで読んでくれて、ありがとうございます。
ここまで読んでくれたあなたは、もう「出会い系で失敗しない知識」を十分に持っています。
あの休日の夜を変えるのは、たぶん大した決断じゃないんです。
スマホで3分、無料登録するだけ。
だから今日、1つだけアプリを開いてみてください。
中を覗くだけでいい。
その一歩が、休日の夜を変える最初の一歩になります。
よくある不安、ぜんぶ答えます【FAQ】
ここまで読んでくれたあなたは、たぶんもう「やってみようかな」と思い始めてるんじゃないでしょうか。
でも、頭の片隅にまだモヤモヤが残ってる。
そのモヤモヤ、ここで全部潰しておきましょう。
- 身バレしない?
-
基本的にしません。
私は最初、写真なしで始めました。それでもメッセージのやりとりはできたし、信頼できそうな相手にだけ後から写真を送る、というやり方で問題なく使えました。
- お金はどれくらいかかる?
-
月3,000〜5,000円が目安です。
目安としては、週に3〜5人にメッセージを送るペースで、月3,000〜5,000円くらい。飲み会1回分です。合コンに1回行くより安い。
- 既婚でも使える?
-
アプリによります。
PCMAX、ハッピーメール、ワクワクメール、Jメール、イククル──今回紹介した5つは、いずれも「既婚者の登録を禁止していない」出会い系アプリです。
- 写真載せたくないけどいい?
-
載せなくても使えます。ただし、マッチ率は下がります。
ただ正直に言うと、写真ありと写真なしでは、メッセージの返信率に2〜3倍の差が出ます。相手の立場で考えれば当然です。
顔がわからない人にメッセージを返すのは、やっぱり勇気がいりますようね。
- ロマンス詐欺に引っかからないか不安です
-
ここを読んでくれていれば、もう大丈夫です。
私はロマンス詐欺に引っかかりかけた経験があるからこそ断言しますが、「知っている」と「知らない」で、被害に遭う確率はまったく違います。 あなたはもう知っている。だから大丈夫です。






コメント